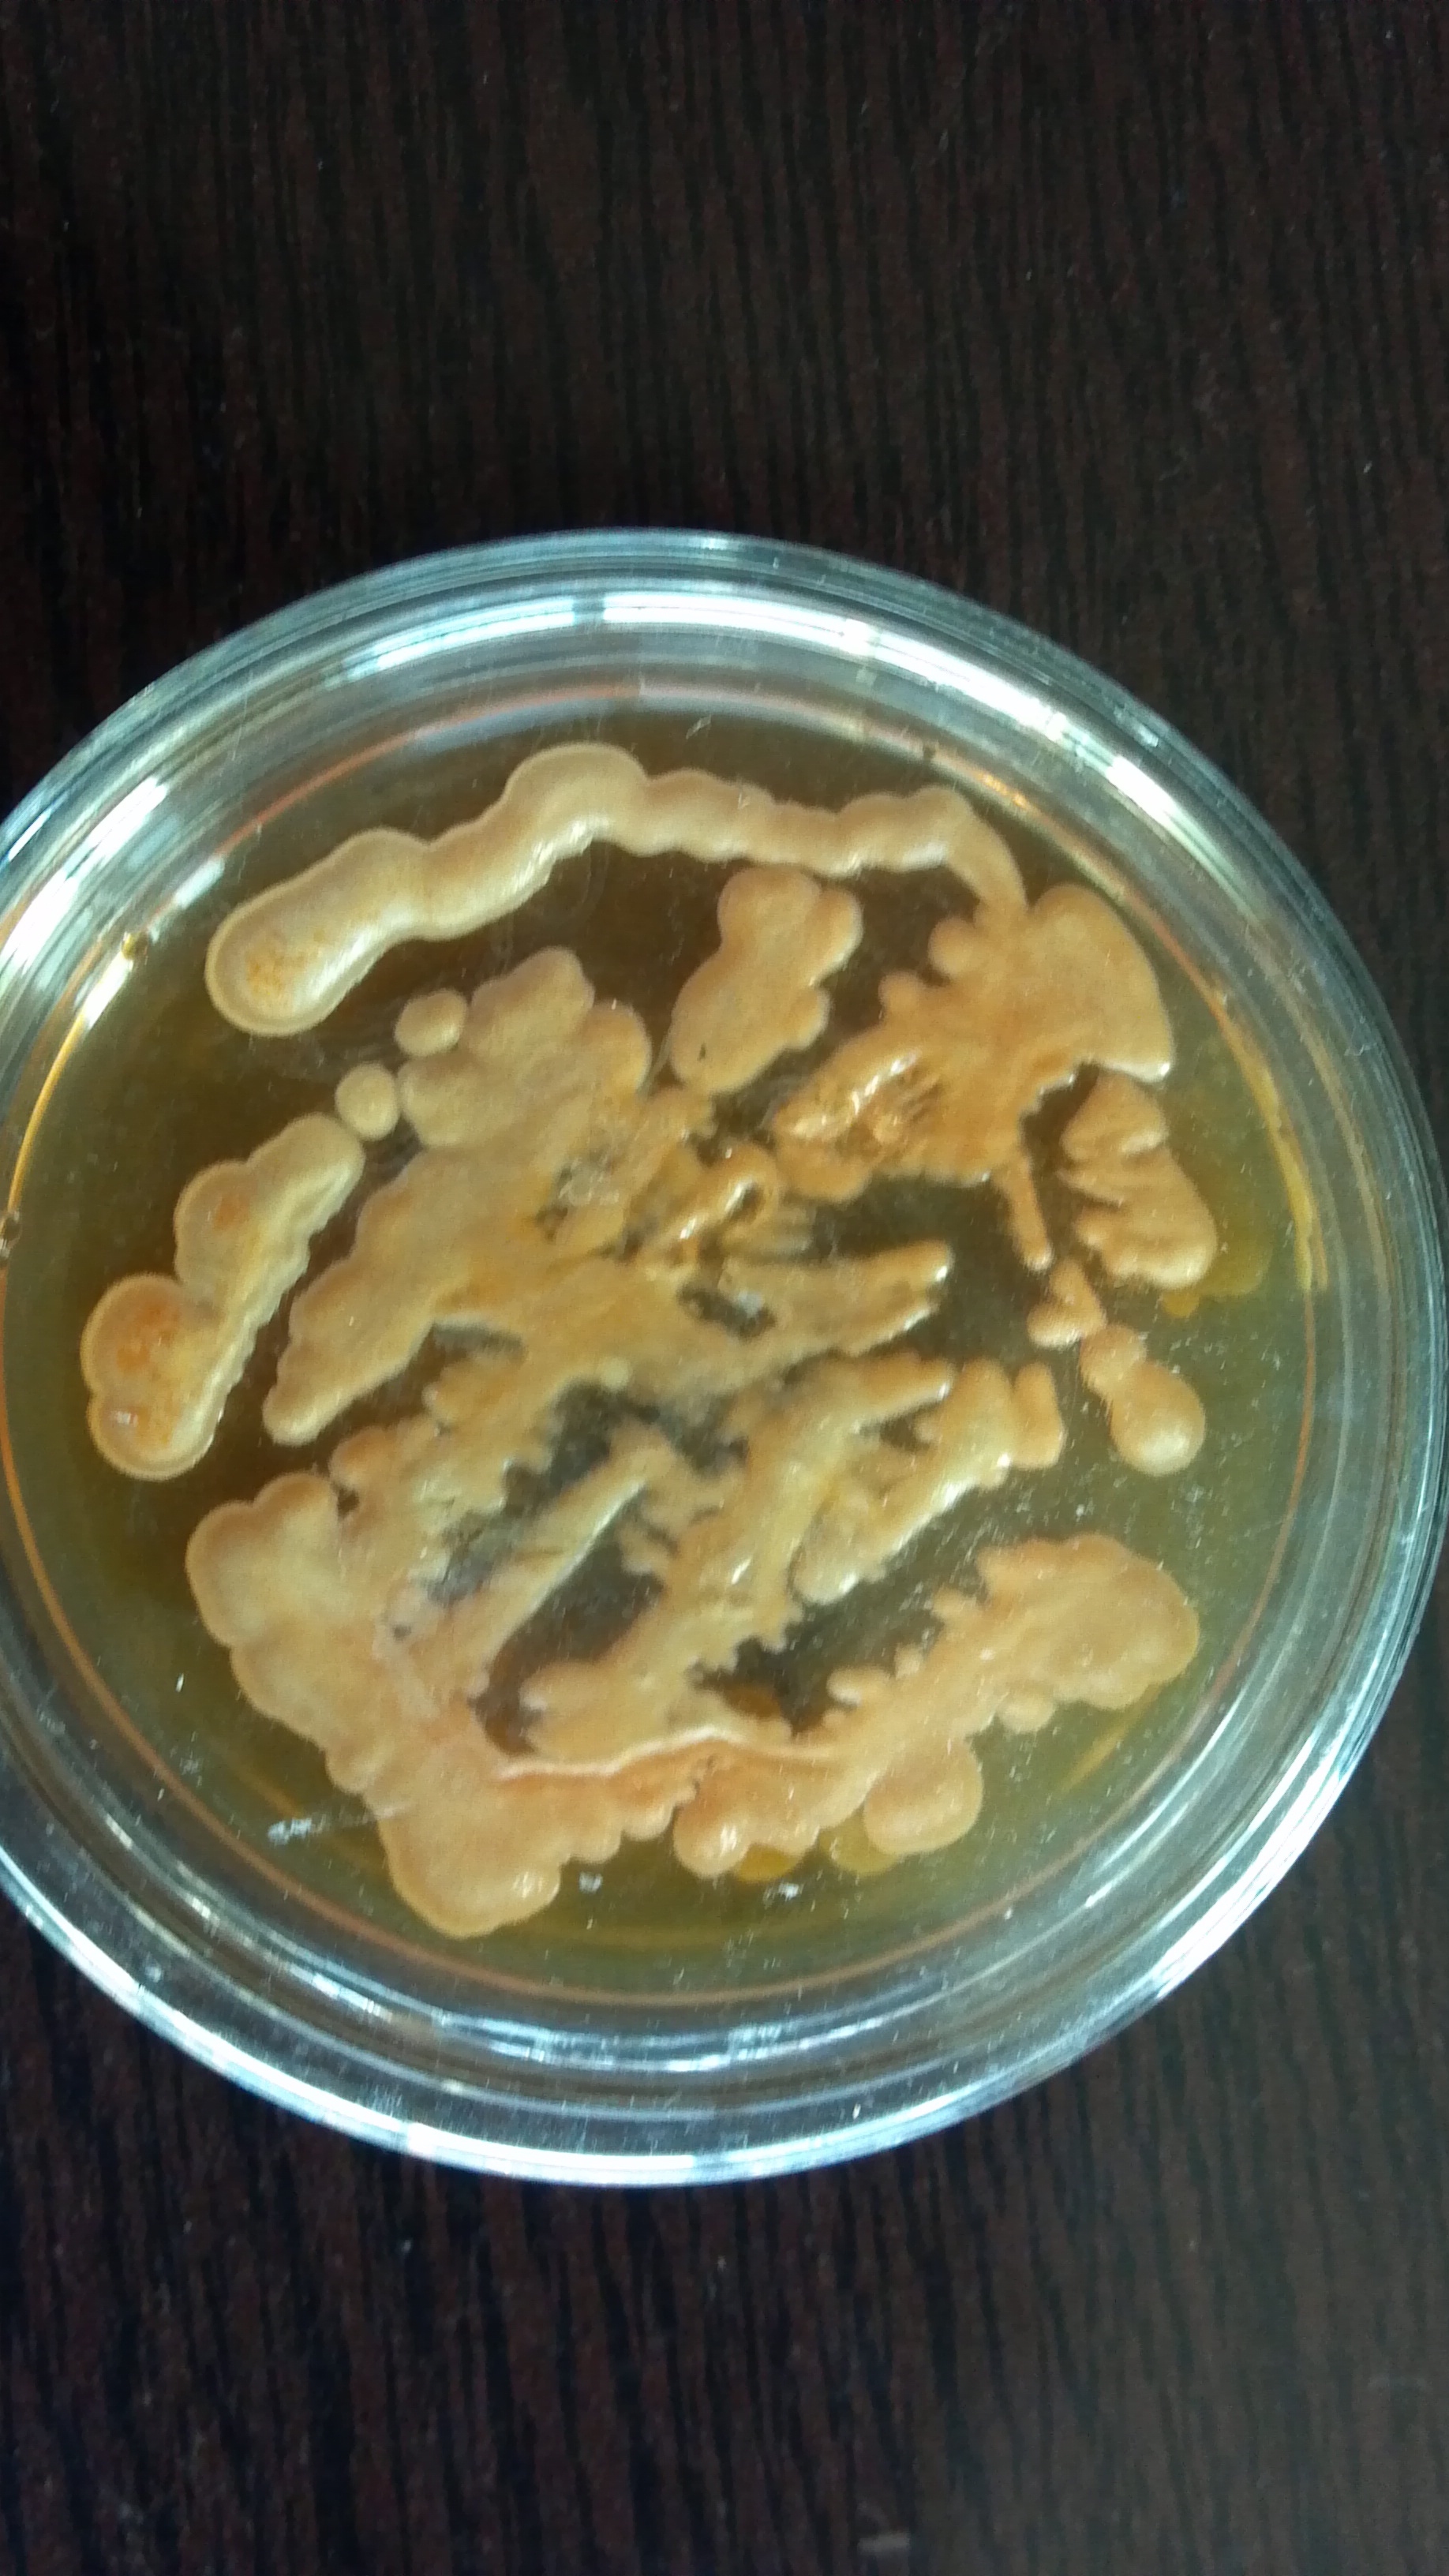

土壤经过多年的不当耕作引起土质退化,在低肥力土壤当中,补充有益微生物是解决土壤低肥力的一种有效手段,微生物在培肥地力上有如下作用:
1.土壤微生物既是土壤形成的参与者,又是土壤的重要组成部分
肥土中每克土含几亿至几十亿个微生物,贫瘠土每克土含几百万至几千万个微生物。土壤中栖息着多种多样的微生物,具有不同的生理活性,营各式各样的生活。土壤微生物的代谢机能非常多样化,儿乎能代谢生物合成的所有有机物。或者将它们矿化为二氧化碳以及氮、硫、磷等元素的无机物;或者把一种有机物变为另一种形态的有机物,例如,多糖转化为单糖。单糖转化为多糖;或者把一种无机物转化为另一种无机物,如硝化作用;或者把无机物转化为有机物,如固氮作用。细菌可以产生胞外代谢物,通过胶结作用稳定团聚体。放线菌和真菌主要参与土壤有机质分解过程,放线菌能够分解有机质及多数真菌和细菌不能分解的化合物;真菌能分解纤维素、半纤维素、木质素,亦能分解蛋白质并释放氨。微生物类群在团聚体形成中的作用是:真菌>放线菌>细菌。此外,微生物细胞作为一种带负电荷的胶体物质也可借助静电引力促使土壤颗粒彼此连结在一起。十几壤微生物复杂多样的代谢方式保证了碳、氮、氧、氢、磷、硫等元素在生物圈中不同生态系统间的相互传递,对维持十壤肥力也具有重要的意义。土壤微生物的另一主要作用就是促进十壤团粒结构的形成,特别是丝状菌、真菌及放线菌粘结土壤颗粒形成团聚体时作用更明显。土壤有机质只有在微生物的作用下,才具有团聚土粒的作用。Greene等提供的微形态学证据表明,土壤微生物把非结品粘胶状的有机物密切地勃结在一起,而有机物又将矿物细粒进一步联结,形成球状表面团聚体。因此,是否含有一个能尽快释放出养料以保证植物正常生长的微生物群体是评价土壤肥力的一个重要指标。
2.土壤微生物能生活在各种极端环境中,具有广泛的生态适应性。
例如:在降水稀少的荒漠地区,许多耐旱、耐高温的土壤微生物种类仍然能够生活在沙土的表面,在荒漠地表生物结皮各阶段起十分重要的作用。在维持生态系统的结构与功能方面它们也起着十分重要的作用。微生物在其生命活动期间能分解土壤中难溶性的矿物,并把它们转化成易溶性化合物,从而帮助植物吸收各种矿质元素。土壤中含有很多钾细菌和磷细菌,它们能够将土壤矿物无效态的钾和磷释放出来,供植物生长发育用。解磷的微生物种类很多,日前报道的解磷细菌上要有芽抱杆菌属、假单胞菌属、埃希氏菌属、欧文氏菌属及多硫杆菌属等。而真菌的解磷能力一般是细菌的10倍。一般认为,微生物解磷的机制是由于微生物分泌出有机酸,降低了pH值,又可与铁·铝等离子结合,从而使难溶性磷酸盐溶解。据报道,解磷菌的溶磷作用是中低肥力土壤中促进植物生长最重要的机制之一。
研究表明:用EM菌剂拌种处理后,土壤中有机质可增加9.6%一10.7%,碱解氮增加5.1%一7.7%.速效磷增加37.5%一57.0%,速效钾增加33.3%一50.0%,酸碱度稳定,由此说明复合微生物菌剂能促进十壤中各种养分的有效化,增加速效养分的含量。
